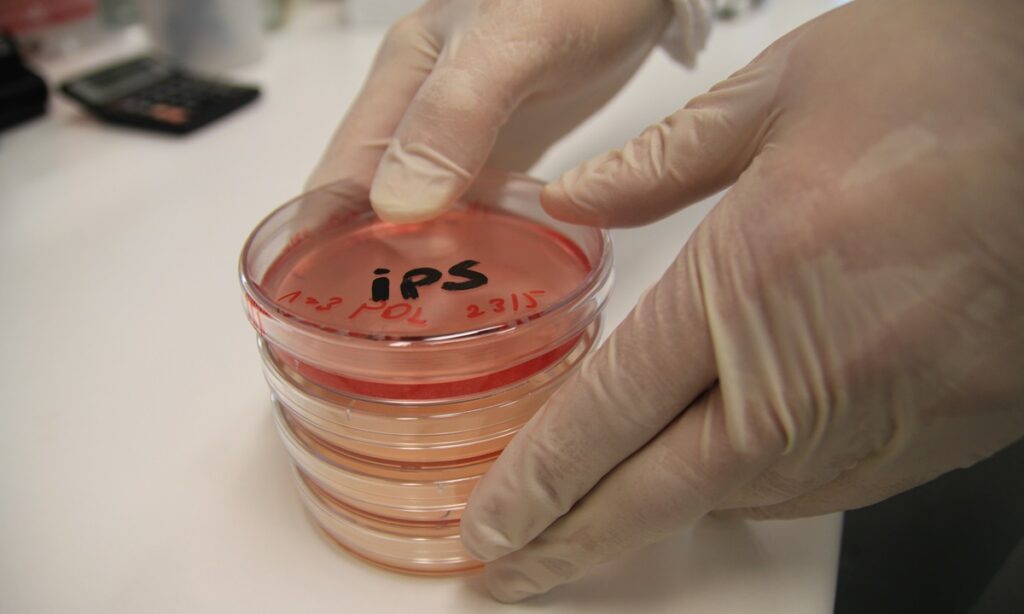

Stem cell multiplication process and associated stem cell injections
Stem cells extraction
Biotechnology laboratory Team
Stem cells multiplication
Stem cells clinic entrance
Stem cells injections

Interested in learning whether current clinical programs, research developments, or emerging therapeutic approaches may be relevant to your situation?
Educational and research information only. Individual medical decisions should be made in consultation with qualified healthcare professionals.